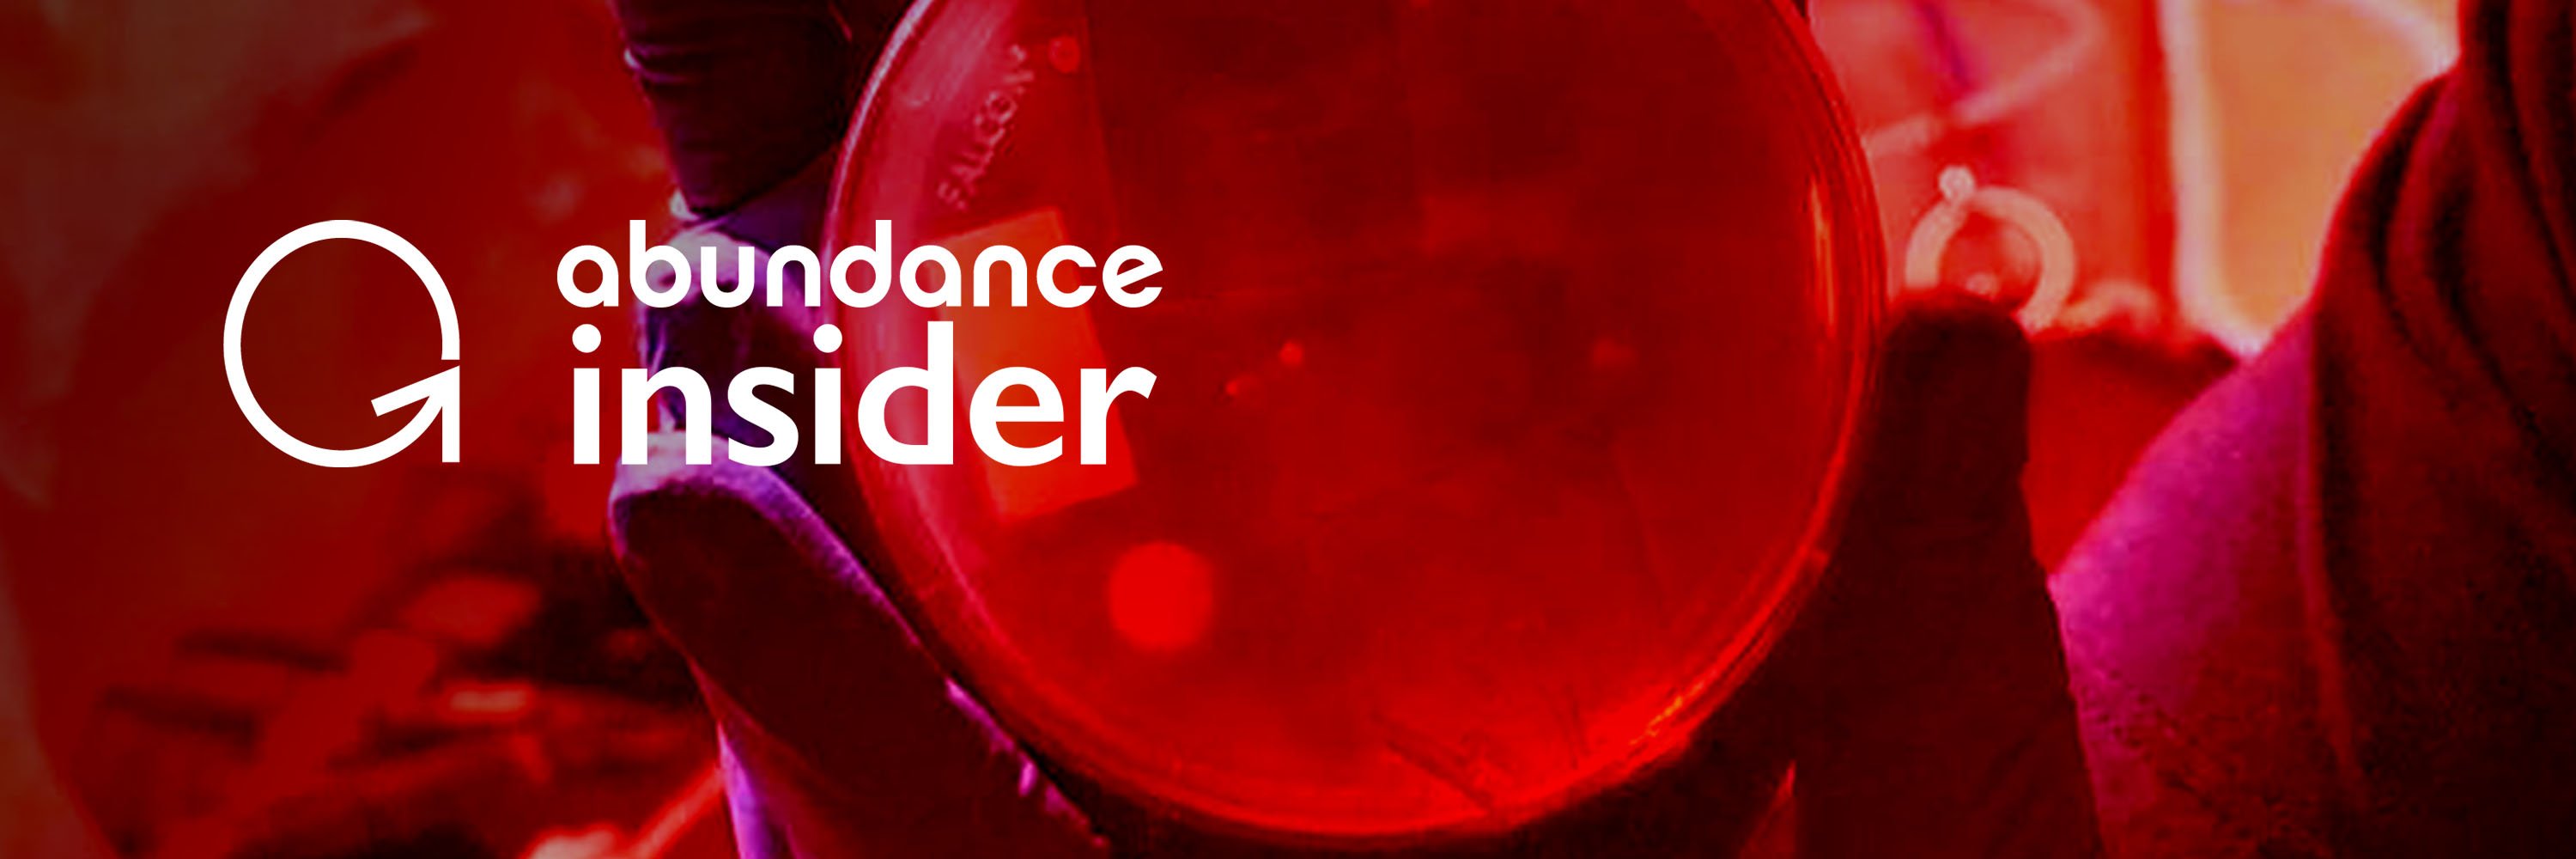

In almost every industry you can think of, blockchain revolution is poised to cut out middlemen, dramatically improve transparency, and multiply the efficiency of countless transactions worldwide.
While most well-known for its application in cryptocurrencies, blockchain is on the cusp of fundamentally revolutionizing supply chains, healthcare, elections, and real estate.
P.S. Send any tips to our team by clicking here, and send your friends and family to this link to subscribe to Abundance Insider.
But what Is blockchain technology, and how does it work?
Blockchains technology emerged in 1991 as a way to timestamp digital documents, but became much more widely-known in 2009 when “Satoshi Nakamoto,” whose true identity is disputed, used blockchain technology to create the cryptocurrency Bitcoin.
A blockchain is a decentralized database shared across a network of computers, or “nodes,” that can only be altered after approval from all nodes in the system. Once information is created in a blockchain, it is very difficult to change.
Each block within a blockchain contains (1) data, (2) the hash, or a digital fingerprint of the block, and (3) the hash of the previous block. Different types of data can be stored within blocks, such as the sender, receiver, and transaction amount in the case of Bitcoin. A block’s hash, which is generated based on the data within that block, changes if its data is altered.
Blockchains are extremely secure for several reasons:
- Because each block contains its own hash and the hash of the previous block, changing one hash will make the rest of the blockchain invalid.
- Proof-of-work is a mechanism that slows the creation of new blocks, requiring about 10 minutes per block in the case of Bitcoin. This delay makes it extremely difficult to recreate an entire blockchain after changing the data of one block.
- Consensus models vet computers seeking to join the blockchain with proof-of-work and proof-of-stake tests. Proof-of-work tests require nodes to solve computational challenges in exchange for tokens, which can then be used in proof-of-stake tests to purchase entry into a blockchain.
Next 5 “Blockchain Breakthroughs” (2019-2024):
One of the most successful entrepreneurs in government and enterprise technology, Eric Pulier is my go-to expert on all things blockchain technology. The best-known venture capital groups in the world have financed companies that Pulier has founded or co-founded, including MediaPlatform, US Interactive, Desktone and SOA Software.
“Blockchain is a new way of looking at value and a new way of creating a transaction between parties where you don’t need a third-party intermediary and can track things and really have trust.”
— Eric Pulier, Founder, CEO, vAtomic
In the next five years, Pulier predicts five blockchain trends, each poised to disrupt major players and birth entirely new business models by 2024.
Let’s dive in…
- Non-fungible tokens (NFTs)
An NFT is a token on the Ethereum blockchain that contains unique metadata that differentiates it from other tokens. While currency is fungible and can be easily transferred, NFTs can be used to store much more complex and individual-specific information.
Government documents such as marriage certificates, land registrars, food-grade ratings, and driver's licenses can all be tokenized using NFTs. In retail, consumers can use blockchain technology to verify the legitimacy of luxury goods. Digital goods and tickets can easily be stored as NFTs on blockchains.
Pulier predicts, “Now, the token, which is like a Bitcoin, can be a ticket, or a coupon, or a collectible. It could represent a real world good, like a coffee or a piece of art. So, what you’re going to see is the emergence of an entirely new space where non-fungible tokens are going to completely change the economy.”
Also read: 10 Years of Change
- Security tokens
Security tokens are cryptographic, programmable securities that serve as an asset that can also take action. Security tokens can pay dividends, pay interest, or even invest in other tokens or assets, among other functions. Smart contracts, for instance, will allow assets to automatically pay dividends on a specific date if criteria are met.
As Pulier explains, “Most of the tokens that you might be familiar with are called utility tokens, and they don’t represent a piece of a real world object or of an actual equity. Security tokens are now emerging this year.” Security tokens have huge potential to decrease liquidity issues but will require additional infrastructure to take hold, such as their own exchanges, Security Token Offerings (STOs), and wallets.
- Tokenized assets
“Everything that you can imagine that doesn’t have liquidity is going to be fractionalized and tokenized and put on exchanges,” predicts Pulier. Over the next five years, security tokens will start to represent a new form of liquidity in assets that traditionally have lacked liquidity, such as real estate or art. Pulier anticipates these assets will start trading 24/7, 365 days a year.
Malta and Switzerland lead the way in developing infrastructure for tokenized assets. The U.S. SEC and EU’s ESMA have begun issuing comments about plans to put regulations in place.
Also read: Future of Insurance
- Self-sovereign identity
As cyberattacks continue to proliferate, new forms of blockchain identity verification will leap onto the scene to protect users. Self-sovereign identity will allow users to maintain a single digital identity across multiple platforms while selecting the information they wish to share on each. This mode of interaction would drastically transform the current digital marketplace that has turned personal data into a commodity.
“Identity is going to be returned through blockchain back to the individual so that the individual will own their data and then be able to marshal it out based on what’s best for them as opposed to how Facebook or Google or other people may want to exploit it,” says Pulier.
In 2014, identity assurance processes cost the U.K. a staggering £3.3 billion. Self-sovereign identity would significantly reduce these costs as well. In e-commerce, online logins will be exponentially more secure and efficient. For financial services, Know-Your-Customer (KYC) and Anti-Money-Laundering (AML) work will be transferable from one bank to another, decimating costs. In healthcare, self-sovereign identifies will put medical history records back into the hands of individual patients, and transparency of permissioned access will become the new standard.
- Free speech
“Blockchain revolution allows you to have an immutable record, something that no government can tear down no matter what, because a distributed ledger all over the world is going to undermine the despots, undermine the organizations and the governments that want to clamp down on free speech, and coupled with ubiquitous bandwidth, create a world where everybody is going to be able to have a voice. No speech is going to be able to be brought down or in some way kept away from the masses,” predicts Pulier.
The trend away from hierarchical societies towards networked structures has become increasingly prevalent over the last few decades. Blockchain revolution will only accelerate this transition across the globe, unleashing profound social impacts. Enabling trust within vast networks of decentralized control, blockchain is about to unlock a phenomenon that few human societies have ever achieved before.
Also read: TOP 50 MOON SHOTS
Final Thoughts
Operating as peer-to-peer decentralized “digital ledgers,” blockchains will reduce the spread of corrupted information, increase transparency, witness multiplied efficiency in countless processes, and cut out unnecessary intermediaries across almost every industry.
Blockchain supply chain will seamlessly record each touchpoint of an item, increasing production transparency for buyers who wish to make more informed purchase decisions. For elections anywhere, blockchain is poised to decentralize the voting process while maintaining fidelity to prevent election hacks. And in real estate, property record histories stored on blockchains will decimate time invested in due diligence and financial verifications.
At the individual level, blockchain technologies will allow you to more easily verify your identity, share your health records, maximize gain from your financial assets, and track the origins of your every purchase.
And at the broader societal level, blockchains will catalyze a sweeping shift away from hierarchical structures towards democratized networks at larger scales than ever before experienced by humankind. A next-generation tool capable of maintaining trust in large populations, blockchain will define a brand new order.
Join Me
(1) A360 Executive Mastermind: Want even more context about how converging exponential technologies will transform your business and industry? Consider joining Abundance 360. Our highly selective community of 360 abundance- and exponentially minded CEOs is on a 25-year journey — or as we call it, a “countdown to the Singularity." If you’d like to join our 2020 membership, apply here.
Share this with your friends, especially if they are interested in any of the areas outlined above.
(2) Abundance-Digital Online Community: I’ve also created a Digital/Online community of bold, abundance-minded entrepreneurs called Abundance-Digital. Abundance-Digital is my ‘onramp’ for exponential entrepreneurs — those who want to get involved and play at a higher level. Click here to learn more.
P.S. I've just released a podcast with my dear friend Dan Sullivan called Exponential Wisdom. Our conversations focus on the exponential technologies creating abundance, the human-technology collaboration, and entrepreneurship. Head here to listen and subscribe.
Topics: Abundance Bitcoin Abundance 360 Real Estate a360 cryptocurrencies blockchain Technology healthcare distributed ledger exponential technology future of real estate tokenizing token crypto NFTs microtransactions smart contracts ethereum